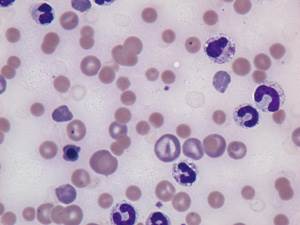

Общий клинический анализ крови у собак
Взятие анализа
Основные показатели общего клинического анализа крови
Общий клинический анализ крови – ОКА крови – это анализ, который оценивает клеточный состав крови и является обязательной частью комплексного обследования больного животного и одним из основных исследований при диспансеризации.
Взятие анализа
Взятие анализа происходит следующим образом:
- Взятие ОКА крови происходит в специальную пробирку с веществом, препятствующим свертыванию крови (ЭДТА – Этилендиаминтетрауксусная кислота ), так как свертывание крови приводит к склеиванию клеток крови в сгусток и лаборанту не удастся провести данный анализ.
- Часто ОКА крови советуют сдавать натощак, но это не обязательно.
- Собака при сборе анализа фиксируется в положении лежа на боку или на животе или стоя, в зависимости от выбора вены, из которой будет проводиться сбор анализа. Чаще всего используются подкожная вена предплечья (на передней лапе) или малая подкожная вена бедра (на задней лапе). Жгутом зажимается лапа выше места инъекции, шерсть с поверхности вены может быть сострижена и место венопункции обработано спиртовым раствором.
- Анализ крови собирается в пробирку, место инъекции зажимается ватой и перевязывается бинтовой повязкой на
5-10 минут. - Общий объем крови для ОКА крови обычно составляет
1-3 мл, на месте инъекции не остается ран, и поэтому данная процедура безболезненна и не опасна для собаки. - Нормы показателей крови варьируются в зависимости от лаборатории, куда сдавался анализ, ее технического оснащения. Обычно, нормы для собак прилагаются как расшифровка в каждом результате ОКА крови.
Основные показатели общего клинического анализа крови

HB – гемоглобин.
Это сложный железосодержащий белок, который содержится в эритроцитах. Чаще всего его показатели важны для диагностики анемий у животных.
RBC – эритроциты.
Это красные кровяные тела, количество которых исследуется также для диагностики анемий у животных.
Ht – гематокрит.
Гематокрит – это соотношение объема эритроцитов к объему жидкой части крови. С помощью данного показателя ветеринарным специалистом принимается решение о переливании крови, оценивается степень обезвоживания у животного, анемия.
Pl – тромбоциты.
Это мелкие плоские бесцветные клетки крови, основной функцией которых является участие в процессах свертывания. Уровень тромбоцитов исследуется для исключения проблем со свертыванием у животных.
WBC – лейкоциты.
Лейкоциты – это белые клетки крови, выполняющие защитные функции. К лейкоцитам относят нейтрофилы, эозинофилы, базофилы, лимфоциты, моноциты. Повышение общего числа лейкоцитов в анализе крови – говорит о лейкоцитозе, или общем воспалении в организме. Когда они понижены, говорят о лейкопении.
СОЭ – скорость оседания эритроцитов.
СОЭ также используется как дополнительный маркер воспалительного процесса в организме собаки, однако у животных этот показатель имеет ограниченную диагностическую ценность.
Палочкоядерные нейтрофилы.
Этот тип лейкоцитов, достаточно недолго существующих в организме – молодые (незрелые) формы лейкоцитов. Их высокое количество наряду с лейкоцитозом может указывать на острый воспалительный процесс (случившийся недавно и развивающийся быстро).
Сегментоядерные нейтрофилы.
Эти клетки – самая зрелая стадия нейтрофилов. По их количеству судят о длительности воспалительного процесса, тяжести инфекционной болезни.
Базофилы.
Эти клетки активно участвуют в аллергических реакциях, в фагоцитозе при инфекционных болезнях.
Моноциты.
Моноциты – это макрофаги, главной функцией которых является фагоцитоз. Моноциты активируются при проникновении инфекции в организм и участвуют в стимуляции иммунной системы и осуществляют противоопухолевый, противопаразитарный, противомикробный иммунитет. Опираясь на общее количество моноцитов можно оценить реакцию организма на инфекционное заболевание.
Лимфоциты.
Эти клетки обеспечивают иммунную защиту в организме. Увеличение общего количества лимфоцитов происходит при острой и хронической инфекции, а также может быть симптомом лимфомы у собаки.
Чаще всего эозинофилы являются маркером аллергических заболеваний или паразитарной инвазии у собак.
Варшавское шоссе, 125 стр.1. тел. 8 (499) 372-27-37
Почитайте отзывы о нашем ветеринарном центре.
Позвоните по номеру 8 (495) 241 64 95 и запишитесь на консультацию прямо сейчас.
(с) Ветеринарный центр лечения и реабилитации животных «Зooстатус».
Варшавское шоссе, 125 стр.1.

